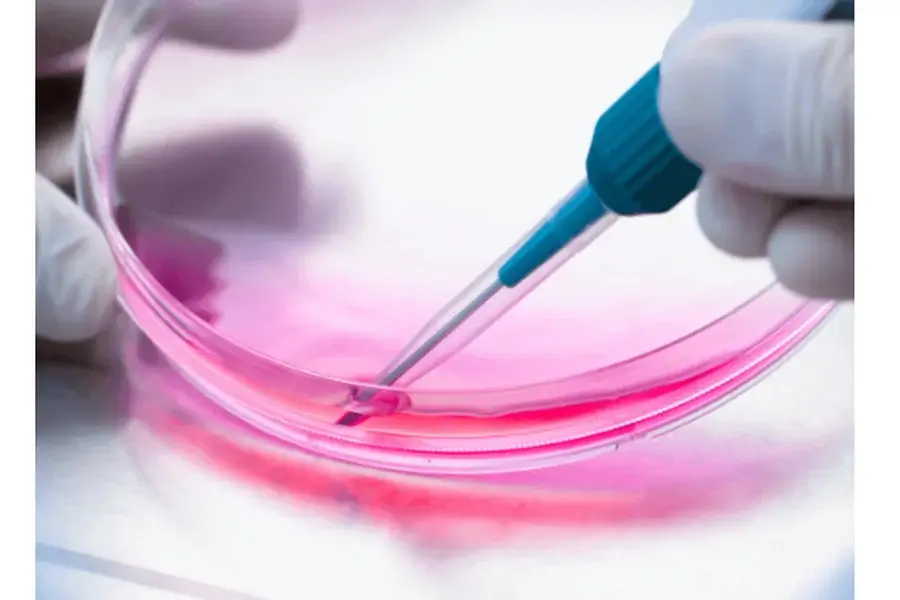
Intrathecal Injection: Safety and Best Practices Maintain strict aseptic technique and post-operative care

Intrathecal (IT) injection has become a critical technique in preclinical and clinical research for central nervous system (CNS) therapies. By delivering drugs directly into the cerebrospinal fluid (CSF), IT administration bypasses the blood–brain barrier and allows for targeted, efficient exposure. This unique advantage also brings challenges: precise technique, dose control, and safety monitoring are essential to protect both data quality and patient or animal welfare. Developing and following best practices ensures high reproducibility and minimizes complications in CNS drug studies.
Safety and Best Practices in Intrathecal Injection
To optimize it injection outcomes, researchers and clinicians must address the core factors that determine procedural safety and data consistency.
Ensure anatomical precision in catheter placement.
Successful IT administration hinges on accurate targeting of the subarachnoid space. In small animals like rats, narrow interspaces and limited CSF volume make blind lumbar punctures prone to error. Catheter-based techniques, such as guidewire-guided lumbar catheterization, significantly improve accuracy and reduce the risk of cord injury. Standardized placement methods minimize operator-dependent variability, leading to higher success rates and consistent pharmacokinetic (PK) outcomes.
Control dose volume and infusion rate.
CSF physiology demands careful attention to volume and flow rate. Over-infusion can elevate intrathecal pressure, causing neurological side effects, while very small doses risk inaccuracy due to catheter dead space. Studies suggest maintaining rat IT volumes below 100 µL and tailoring infusion rates to match drug clearance kinetics. Bolus injections may maximize CNS exposure, while controlled infusions may reduce toxicity. Calibrating these parameters is key to balancing efficacy and safety.
Select species models with translational relevance.
Rodents remain essential for mechanistic studies, but their rapid CSF turnover and enzyme activity often exaggerate clearance. Non-human primates (NHPs), with CSF dynamics closer to humans, serve as valuable translational models for validating oligonucleotides, peptides, or biologics. By comparing across species, researchers can better predict human outcomes while respecting ethical and cost considerations.
Maintain strict aseptic technique and post-operative care.
Infection and inflammation are major risks with IT catheterization. Aseptic surgical fields, sterile solutions, and meticulous catheter fixation reduce complications such as granuloma, thrombosis, or bacterial contamination. Post-operative monitoring should include body weight, pain scoring, and mobility assessments to detect complications early. Humane endpoints and well-documented standard operating procedures (SOPs) protect animal welfare and ensure regulatory compliance.
Optimize formulations for CNS compatibility.
Drug formulations must be tailored for IT use. Solutions should have physiologic pH and osmolality, be free of particulates, and avoid preservatives or excipients that irritate meninges. For sticky or large molecules, adsorption to catheter materials may lower exposure, requiring low-binding plastics or small surfactant additions. Attention to these details preserves both safety and drug stability in vivo.
Use bioanalytical verification for delivery success.
Assuming successful delivery can compromise data integrity. Instead, researchers should validate with CSF sampling or drug concentration analysis. Advanced platforms like LC-MS/MS or ICP-MS ensure sensitive and reliable measurement of drug levels in plasma and CSF. These confirm true intrathecal exposure, differentiate systemic “leak-back,” and provide quantitative support for PK/PD correlations.
Standardize protocols to enhance reproducibility.
Intrathecal procedures are inherently operator-sensitive. Training logs, equipment calibration, infusion pump checks, and consistent catheter selection help minimize variability. Positive controls, repeatability tests, and robust documentation ensure high data quality across studies and enable regulatory submissions with confidence.
Conclusion
Intrathecal injection offers unparalleled access to CNS targets, but its complexity demands rigorous attention to safety and best practices. Accurate catheter placement, careful dosing, aseptic technique, and reliable bioanalytical validation form the backbone of successful IT protocols. By standardizing procedures and anticipating translational differences, researchers and clinicians can maximize therapeutic potential while minimizing risk. Adopting these strategies not only ensures high-quality data but also accelerates the safe development of innovative CNS therapies.